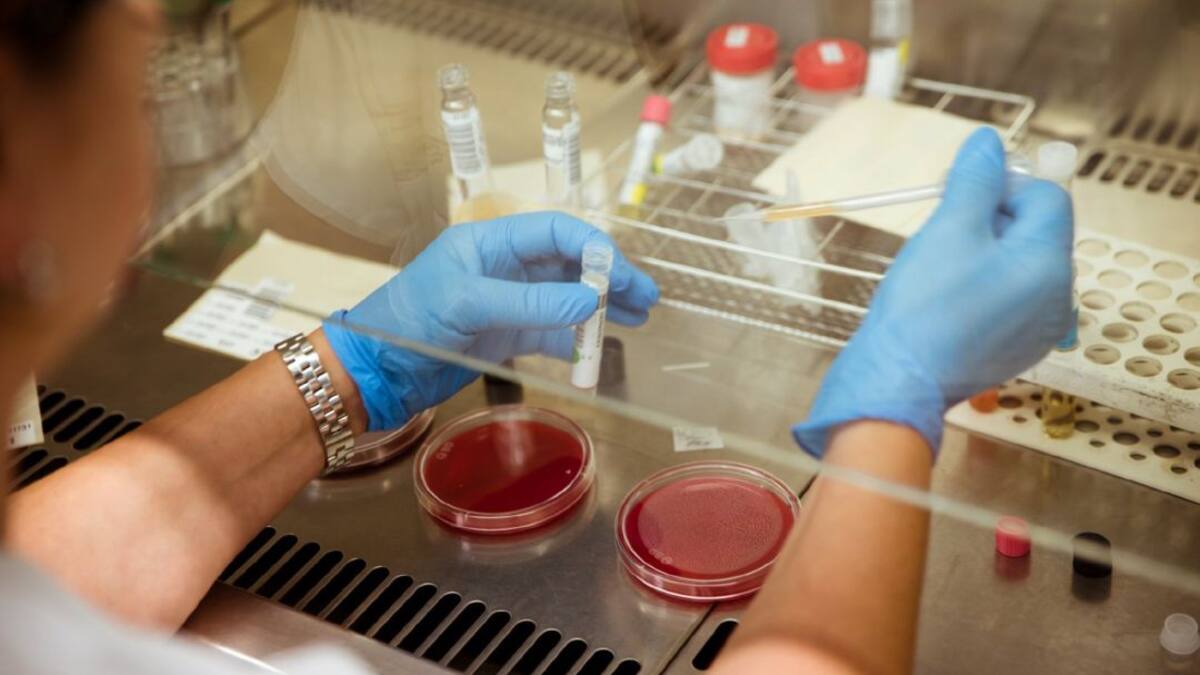
Experimentos científicos para seguir aprendiendo durante la crisis del coronavirus

Sergio Valdés
Periodista, desde 2015 en la SER. Especializado en la información deportiva de Salamanca y provincia, pero atento a cualquier tema informativo que surja. Graduado en Comunicación Audiovisual por la Universidad de Salamanca.
03/04/2020
02/04/2020

Salamanca suma dos máximos en la crisis del coronavirus: el número de muertes y de altas en un día
Repasamos los principales detalles relacionados con la pandemia derivada de la propagación del virus SARS-CoV-2
02/04/2020 - 11:34
Sergio Valdés
Salamanca
01/04/2020

A la cárcel por agredir a agentes policiales cuando les pidieron cumplir el estado de alarma en Salamanca
Los hechos fueron puestos en conocimiento del Juzgado de Instrucción número 4 de Salamanca
01/04/2020 - 09:25
Sergio Valdés
Salamanca
30/03/2020

Semana invernal para iniciar abril en la provincia de Salamanca
La nieve podría ser, de nuevo, protagonista estos días en la capital salmantina
30/03/2020 - 10:46
Sergio Valdés
Salamanca
29/03/2020

Salamanca suma en solitario más casos de COVID 19 que las Islas Baleares, Cantabria o la Región de Murcia
Con datos oficiales de este domingo, facilitados por el Ministerio de Sanidad y la Junta de Castilla y León
29/03/2020 - 13:51
Sergio Valdés
Salamanca
28/03/2020

Santa Marta, Ciudad Rodrigo y Alba de Tormes, las zonas más afectadas por el COVID 19 tras la capital
Repasamos cuáles son las áreas de salud más afectadas en la provincia de Salamanca por el coronavirus
28/03/2020 - 11:48
Sergio Valdés
Salamanca
27/03/2020
26/03/2020

El centro cívico de Vistahermosa, listo para acoger a personas sin acogar con COVID-19
Así será gracias a la ayuda de la organización Cruz Roja
26/03/2020 - 10:30
Sergio Valdés
Salamanca
25/03/2020
24/03/2020

Muere una sanitaria en Salamanca con posible contagio por coronavirus
La fallecida estaba esperando el resultado de la prueba del COVID 19
24/03/2020 - 21:24
Sergio Valdés
Salamanca
23/03/2020

El coronavirus y Salamanca: las cifras de la provincia más afectada de Castilla y León
Este lunes se ha confirmado el peor dato de toda la serie de la provincia: 89 nuevos casos en apenas 24 horas
23/03/2020 - 20:23
Sergio Valdés
Salamanca